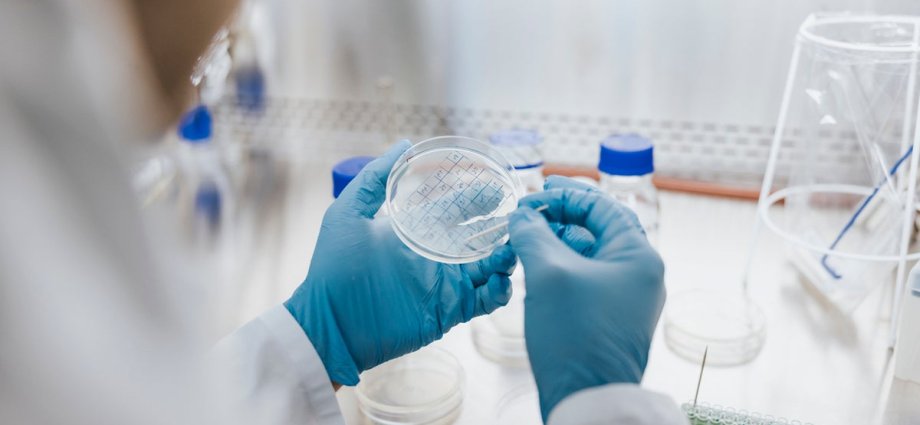

A killer fungus is set to spread through new parts of Europe due to rising temperatures, according to new climate change research.
Aspergillus, a type of mould which can cause lung and breathing problems if it infects a human, may infect millions of people a year as it spreads to more northerly countries in Europe, Asia and America due to rising temperatures, the study shows.
Norman van Rhijn, the Wellcome Trust research fellow at Manchester University who co-authored the study, said the world is nearing a tipping point regarding the rise of fungal pathogens, which thrive in a large variety of environments including inside houses.
Fungal infections will be a factor in millions of deaths worldwide each year, Mr Rhijn said.
Aspergillosis, the lung disease caused by spores of Aspergillus which can spread to other human organs, is one such disease.
Speaking to the FT, Mr Van Rhijn said: “We’re talking about hundreds of thousands of lives, and continental shifts in species distributions. In 50 years, where things grow and what you get infected by is going to be completely different.”
Aspergillus can have positive benefits and is used in industrial and food production, including the fermentation of soy sauce and sake.
Inhaling its spores does not make everyone ill, but the deadly fungus can be particularly threatening to those with conditions such as asthma, cystic fibrosis or a weakened immune system.
But fungal research shows Aspergillus fumigatus could spread across an additional 77 per cent of territory by the year 2100 as a result of the world’s heavy use of fossil fuels, potentially exposing nine million people in Europe to the infection, according to the FT.
The species can grow quickly in high temperatures in compost, explaining why it thrives in the 37C internal temperature of the human body.
“Its lifestyle in the natural environment may have provided Aspergillus fumigatus with the fitness advantage needed to colonise human lungs,” said professor Elaine Bignell, co-director at the MRC Centre for Medical Mycology at Exeter University.
Another species, aspergillus flavus, lives on crops and could spread to an added 16 per cent of territory in north China, Russia, Scandinavia, and Alaska by 2100, researchers added. Some existing areas in African countries and Brazil may also be made inhospitable – which could be damaging to local ecosystems.
Darius Armstrong-James, professor of infectious diseases and medical mycology at Imperial College London, told the FT: “There are serious threats from this organism both in terms of human health and food security.”